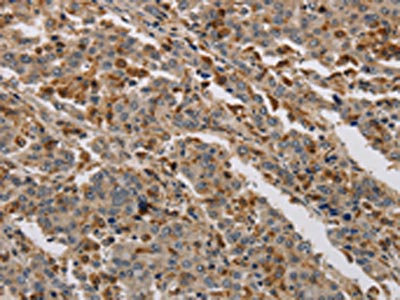

KDM4A Antibody
-
中文名稱:KDM4A兔多克隆抗體
-
貨號:CSB-PA557005
-
規格:¥1100
-
圖片:
-
The image on the left is immunohistochemistry of paraffin-embedded Human esophagus cancer tissue using CSB-PA557005(KDM4A Antibody) at dilution 1/40, on the right is treated with synthetic peptide. (Original magnification: ×200)
-
The image on the left is immunohistochemistry of paraffin-embedded Human liver cancer tissue using CSB-PA557005(KDM4A Antibody) at dilution 1/40, on the right is treated with synthetic peptide. (Original magnification: ×200)
-
Gel: 6%SDS-PAGE, Lysate: 40 μg, Lane 1-2: NIH/3T3 cells, mouse liver tissue, Primary antibody: CSB-PA557005(KDM4A Antibody) at dilution 1/650, Secondary antibody: Goat anti rabbit IgG at 1/8000 dilution, Exposure time: 5 minutes
-
-
其他:
產品詳情
-
Uniprot No.:
-
基因名:KDM4A
-
別名:JHDM3A antibody; JmjC domain containing histone demethylation protein 3A antibody; JmjC domain-containing histone demethylation protein 3A antibody; JMJD2 antibody; JMJD2A antibody; jumonji C domain containing histone demethylase 3A antibody; Jumonji domain containing 2 antibody; Jumonji domain containing 2A antibody; Jumonji domain containing protein 2A antibody; Jumonji domain-containing protein 2A antibody; KDM4A antibody; KDM4A_HUMAN antibody; KIAA0677 antibody; Lysine (K) specific demethylase 4A antibody; Lysine-specific demethylase 4A antibody; TDRD14A antibody; Tudor domain containing 14A antibody
-
宿主:Rabbit
-
反應種屬:Human,Mouse
-
免疫原:Synthetic peptide of Human KDM4A
-
免疫原種屬:Homo sapiens (Human)
-
標記方式:Non-conjugated
-
抗體亞型:IgG
-
純化方式:Antigen affinity purification
-
濃度:It differs from different batches. Please contact us to confirm it.
-
保存緩沖液:-20°C, pH7.4 PBS, 0.05% NaN3, 40% Glycerol
-
產品提供形式:Liquid
-
應用范圍:ELISA,WB,IHC
-
推薦稀釋比:
Application Recommended Dilution ELISA 1:2000-1:10000 WB 1:500-1:2000 IHC 1:50-1:200 -
Protocols:
-
儲存條件:Upon receipt, store at -20°C or -80°C. Avoid repeated freeze.
-
貨期:Basically, we can dispatch the products out in 1-3 working days after receiving your orders. Delivery time maybe differs from different purchasing way or location, please kindly consult your local distributors for specific delivery time.
-
用途:For Research Use Only. Not for use in diagnostic or therapeutic procedures.
相關產品
靶點詳情
-
功能:Histone demethylase that specifically demethylates 'Lys-9' and 'Lys-36' residues of histone H3, thereby playing a central role in histone code. Does not demethylate histone H3 'Lys-4', H3 'Lys-27' nor H4 'Lys-20'. Demethylates trimethylated H3 'Lys-9' and H3 'Lys-36' residue, while it has no activity on mono- and dimethylated residues. Demethylation of Lys residue generates formaldehyde and succinate. Participates in transcriptional repression of ASCL2 and E2F-responsive promoters via the recruitment of histone deacetylases and NCOR1, respectively.; Crucial for muscle differentiation, promotes transcriptional activation of the Myog gene by directing the removal of repressive chromatin marks at its promoter. Lacks the N-terminal demethylase domain.
-
基因功能參考文獻:
- MiR150 plays an important role in the development of lung cancer by serving as an oncogene via the SIRT2/JMJD2A signaling pathway. PMID: 29901178
- Data show that lysine demethylase 4 A/B double tudor domains (KDM4A/B DTDs) bind strongly to histone H3 (H3)K23me3. PMID: 27841353
- Generation of 2-hydroxyglutarate by mutated IDH1/2 leads to the activation of mTOR by inhibiting KDM4A. PMID: 27624942
- The present study indicates a novel evidence for JMJD2A in tumorigenesis by upregulating miR372 in liver cancer cells. PMID: 28467776
- JMJD2A regulated aerobic glycolysis by regulating LDHA expression. Therefore, the novel JMJD2A-LDHA signaling pathway could contribute to the Warburg effects in NPC progression. PMID: 28693517
- Findings inidicate a unique breast cancer stem-like cells (BCSC) culture system for drug screening and offer preclinical proof of concept for lysine demethylase 4A (KDM4A) inhibition as a new strategy to treat triple-negative breast cancer. PMID: 28883001
- The pyruvate dehydrogenase kinases (PDKs) PDK1 and PDK3 are direct targets of KDM4A and E2F1 and modulate the switch between glycolytic metabolism and mitochondrial oxidation. PMID: 27626669
- results suggest that KDM4A possesses the potential to act as an oxygen sensor in the context of chromatin modifications, with possible implications for epigenetic regulation in hypoxic disease states PMID: 28051298
- Here we show that JMJD2A, the first identified Jumonji C domain-containing histone demethylase, is the histone demethylase responsible for SUMO-2/3 enrichment on the Kaposi's sarcoma associated herpesvirus genome during viral reactivation PMID: 28212444
- Lgr4 activates Jmjd2a/AR signaling pathway to promote interaction AR with PSA promoter, causing reduction of prostate cancer apoptosis and cell cycle arrest. PMID: 27743893
- We demonstrate the previously unreported inhibitory action of PKF118-310 on KDM4A. Our findings open up the possibility of developing the first KDM4A-specific inhibitors and derivatives. PMID: 27767379
- KDM4A downregulation promotes autophagy in glioma cell lines. PMID: 27514525
- ERG promotes prostate tumorigenesis together with KDM4A through the upregulation of YAP1. A corollary is that KDM4A as well as YAP1 inhibitors may prove beneficial for the therapy of ERG-overexpressing prostate tumors. PMID: 27109047
- In pancreatic neoplasms, miR-137 targets KDM4A mRNA during Ras-induced senescence and activates both p53 and retinoblastoma (pRb) tumor suppressor pathways. PMID: 26904954
- Study demonstrates that JMJD2A contributes to tumorigenesis in non-small cell lung cancer (NSCLC) by regulating miR-150. Additionally, JMJD2A overexpression is associated with a poor prognosis for NSCLC patients. PMID: 26498874
- High KDM4A expression is associated with endometrial cancer progression. PMID: 26397136
- Studies indicate that histone lysine demethylase (JmjC-KDM) KDM4A protein has been implicated in numerous cancers and cardiovascular diseases. PMID: 25832587
- KDM4A is regulated by hsa-mir-23a-3p, hsa-mir-23b-3p, and hsa-mir-137. PMID: 26755726
- these data reveal a JMJD2A/ETV1/YAP1 axis that promotes prostate cancer initiation and that may be a suitable target for therapeutic inhibition. PMID: 26731476
- Results indicate that SCF(Fbxo22)-KDM4A is an E3 ubiquitin ligase that targets methylated p53 and regulates key senescent processes. PMID: 26868148
- This study showed that KDM4A interacts with RNA Polymerase I, associates with active ribosomal RNA genes and is required for serum-induced activation of rDNA transcription. PMID: 26729372
- Jra recruits the HP1a/KDM4A complex to its gene body region upon osmotic stress to reduce H3K36 methylation levels and disrupt H3K36 methylation-dependent histone deacetylation PMID: 25945750
- A coding single-nucleotide polymorphism in lysine demethylase KDM4A associates with increased sensitivity to mTOR inhibitors PMID: 25564517
- KDM4 mediates nutrient-limitation signaling that leads to the transcriptional induction of autophagy. PMID: 25660547
- this review focuses on describing the structure, mechanisms, and function of KDM4A and primarily discusses the role of KDM4A in cancer development and the importance of KDM4A as a potential therapeutic target. [review] PMID: 25633974
- Negative regulation of Sp1 by JMJD2A causes downregulation of Sp1 in highly invasive breast cancer cells. PMID: 25193278
- The data indicate that JMJD2A could promote breast cancer progression through transcriptional repression of the tumor suppressor ARHI. PMID: 24886710
- JMJD2A is a promoter of endometrial carcinoma cell proliferation and survival, and is a potential novel drug target. PMID: 24815446
- Those findings demonstrate that JMJD2A regulates gastric cancer growth and serves as an independent prognostic factor, and implicate that JMJD2A may be a promising target for intervention. PMID: 24802408
- Findings demonstrate that KDM4A overexpression results in site-specific copy gain of regions amplified in human tumors. PMID: 23871696
- analysis of the nickel-induced inhibition of truncated constructs of JMJD2A and JMJD2C histone demethylases using X-ray absorption spectroscopy PMID: 23692052
- JMJD2A regulation has a role in human carcinogenesis through regulation of the G(1)/S transition PMID: 23603248
- The expression of JMJD2A inhibits Ras-mediated CHD5 induction leading to a reduced activity of the p53 pathway. PMID: 23168260
- overexpression of JMJD2A may contribute to breast tumor formation by stimulating ERalpha activity and that JMJD2A may be a breast-relevant oncoprotein. PMID: 22948256
- data indicate that JMJD2A is a novel promoter of colon cancer cell proliferation and survival, which mediates its effects in p53-dependent and -independent ways PMID: 22134899
- JMJD2A gene could result in cell cycle change and proliferation inhibition, and lead to suppress tumor cell invasion and migration. PMID: 21962223
- JMJD2A and AR levels were significantly lower in malignant versus benign urothelium, while increased LSD1 levels were observed in malignant urothelium relative to benign; a significant reduction in all three proteins occurred with cancer stage progression PMID: 21400613
- SKP1-Cul1-F-box and leucine-rich repeat protein 4 (SCF-FbxL4) ubiquitin ligase regulates lysine demethylase 4A (KDM4A)/Jumonji domain-containing 2A (JMJD2A) protein PMID: 21757720
- these results demonstrate that SCF(FBXO22) regulates changes in histone H3 marks and cognate transcriptional control pathways by controlling KDM4A levels PMID: 21768309
- The expression of JMJD2A was upregulated in human hypertrophic cardiomyopathy patients. PMID: 21555854
- The authors show that knockdown of JMJD2A, an H3K9me3 demethylase, attenuates viral titers, whereas its overexpression increases Kaposi's sarcoma-associated herpesvirus reactivation. PMID: 21228229
- JHDM3A(GFP)(701) is a suitable catalytic module that can be targeted, under the control of a guide protein, to specific loci where the chromatin H3K9me3 status and the milieu of gene expression are to be modified. PMID: 21148561
- The ability of JMJD2A to associate with retinoblastoma proteins and histone deacetylase 1 implies an important role for this protein in cell proliferation and oncogenesis. PMID: 15927959
- JMJD2A selectively represses the expression of the achaete scute-like homologue 2 (ASCL2) gene but not other imprinted genes in the same imprinted locus in HeLa cells PMID: 16024779
- crystal structure of the double tudor domain of JMJD2A both in the presence and absence of a trimethylated H3-K4 peptide PMID: 16601153
- JHDM3A may function in euchromatin to remove histone methylation marks that are associated with active transcription PMID: 16732292
- identified two related histone demethylases, JMJD2A and JMJD2D PMID: 17555712
- how human JMJD2A, which is selective towards tri- and dimethylated histone H3 lysyl residues 9 and 36 (H3K9me3/me2 and H3K36me3/me2), discriminates between methylation states and achieves sequence selectivity for H3K9 PMID: 17589501
- Crystal structures of the JMJD2A catalytic domain in complex with H3K9me3, H3K36me2 and H3K36me3 peptides are presented. PMID: 17589523
- Human JMJD2A was expressed in undifferentiated and differentiated ES cells. PMID: 17611647
顯示更多
收起更多
-
亞細胞定位:Nucleus.
-
蛋白家族:JHDM3 histone demethylase family
-
組織特異性:Ubiquitous.
-
數據庫鏈接:
Most popular with customers
-
-
YWHAB Recombinant Monoclonal Antibody
Applications: ELISA, WB, IHC, IF, FC
Species Reactivity: Human, Mouse, Rat
-
Phospho-YAP1 (S127) Recombinant Monoclonal Antibody
Applications: ELISA, WB, IHC
Species Reactivity: Human
-
-
-
-
-